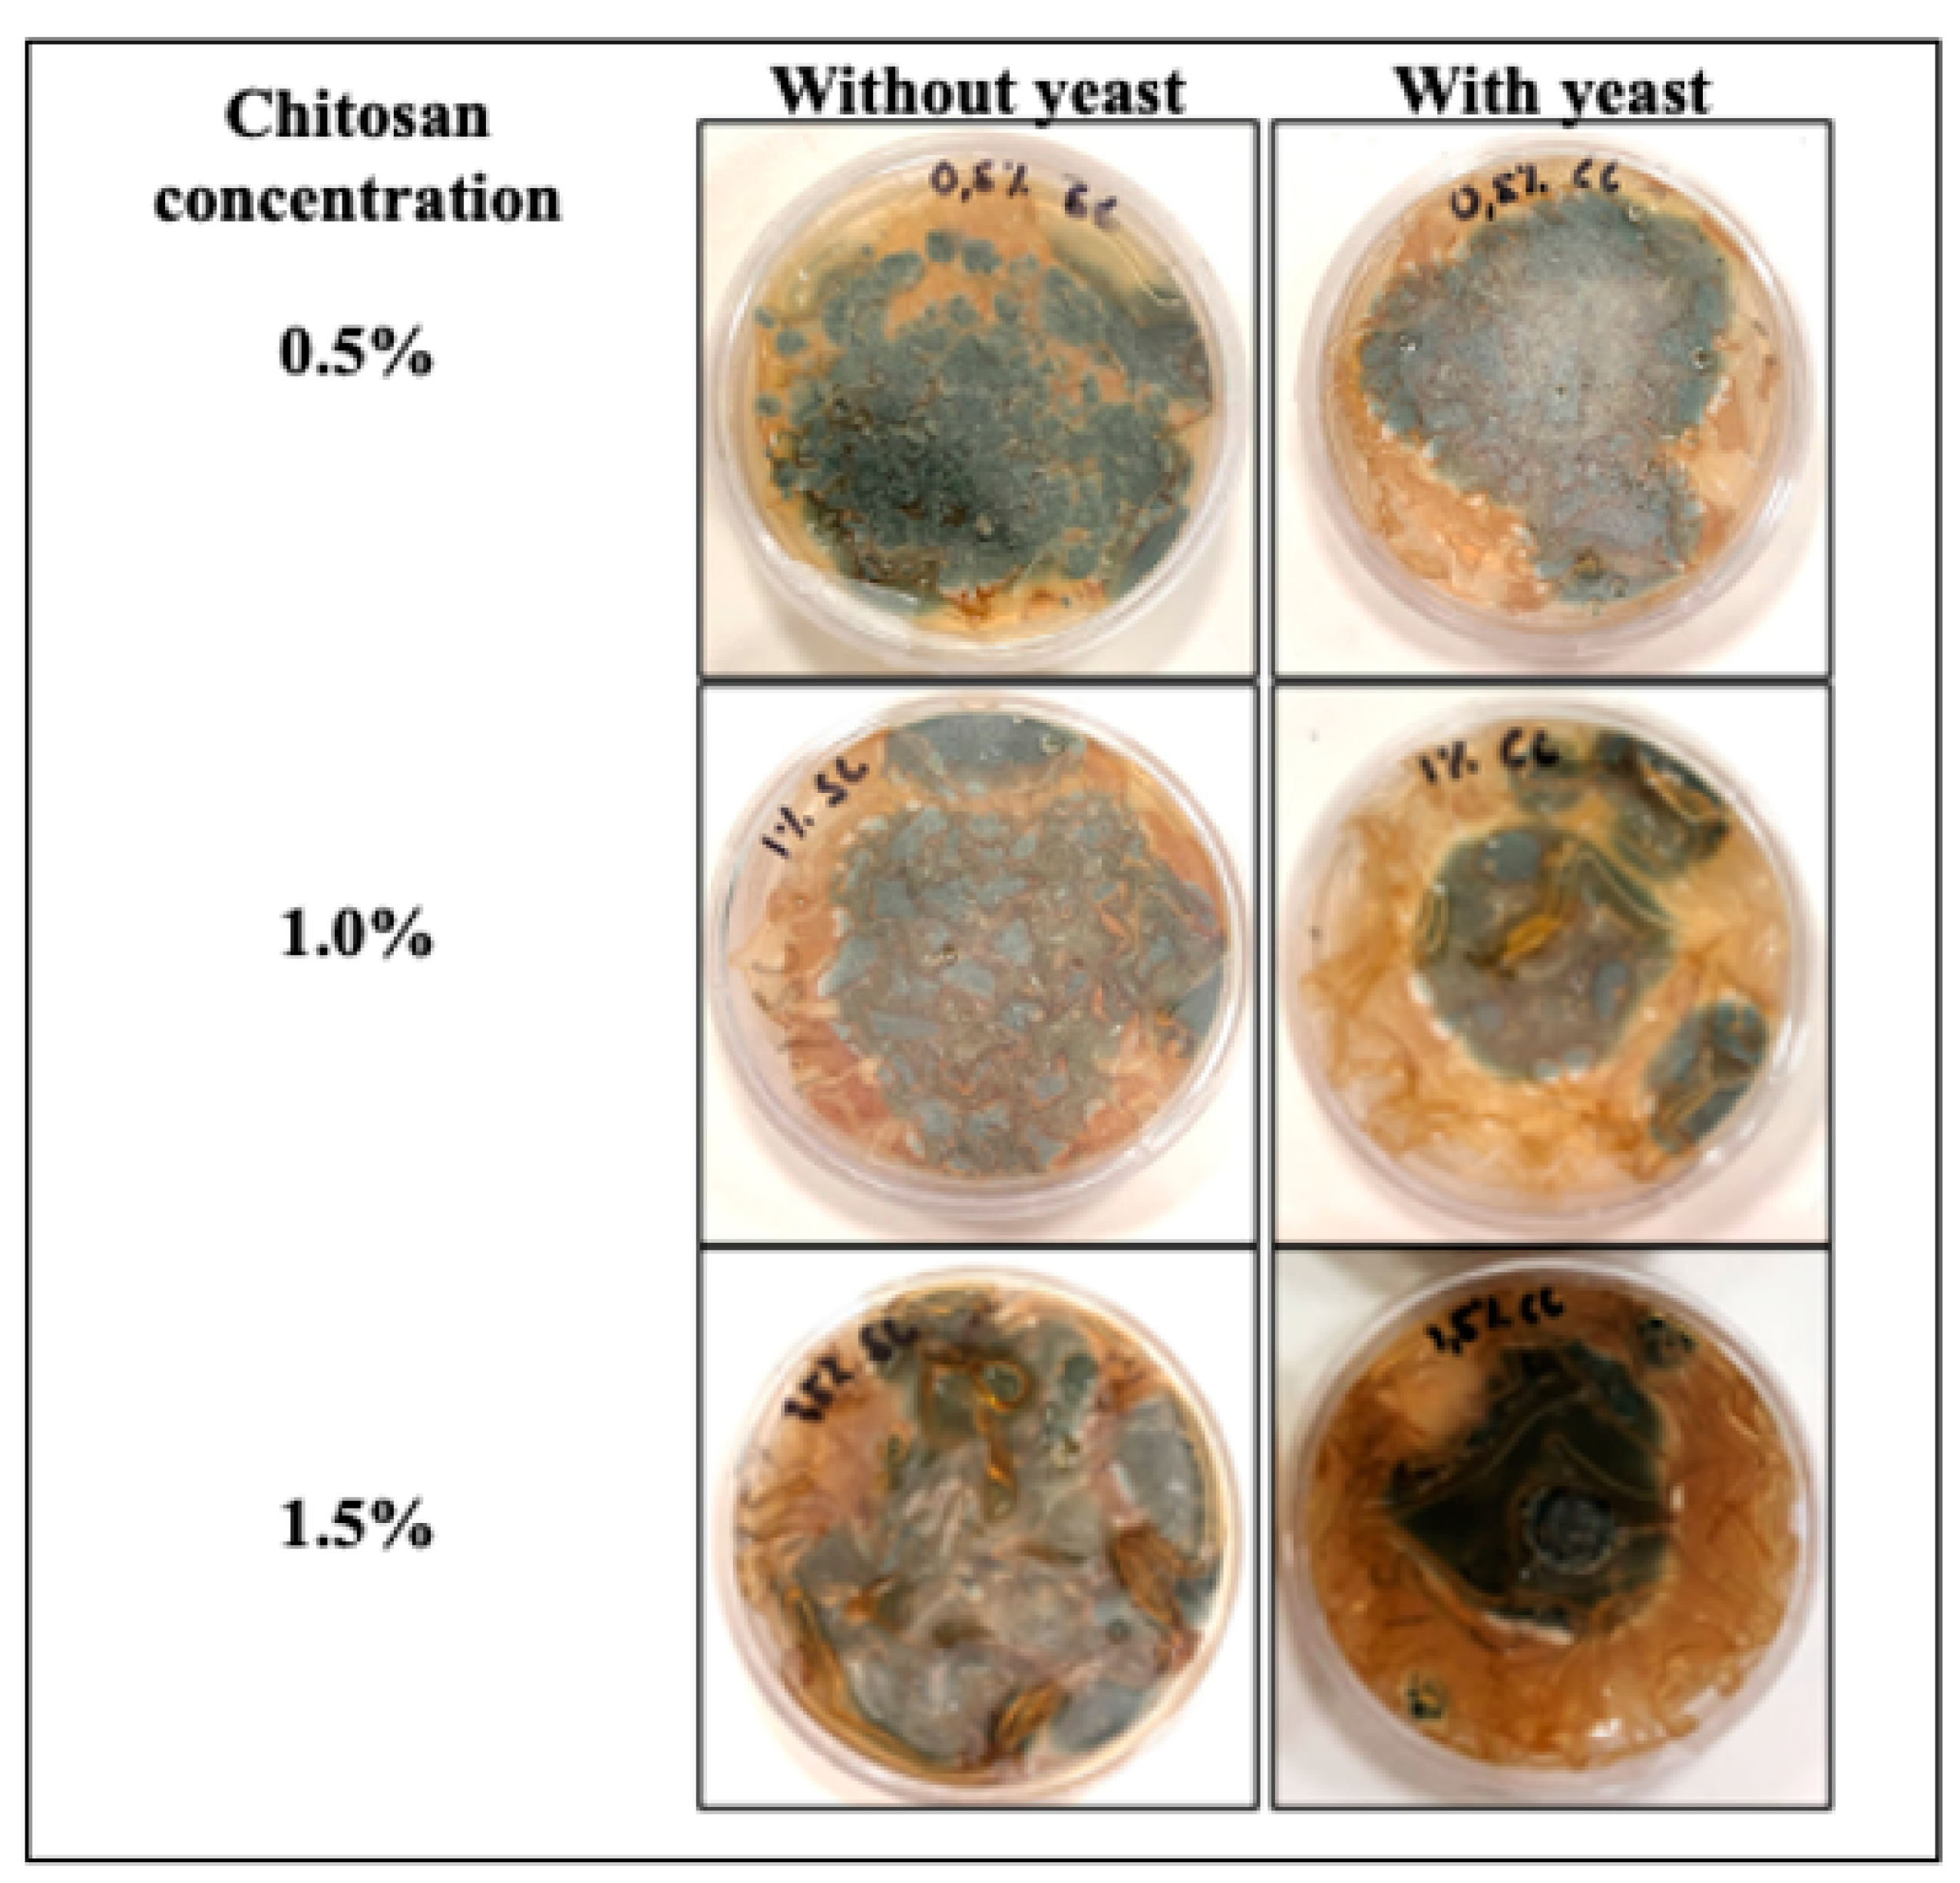
Jof 08 00369 g001

Abstract
Chitosan-based film with and without antagonistic yeast was prepared and its effect against Penicillium italicum was evaluated. The biocompatibility of yeast cells in the developed films was assessed in terms of population dynamics. Furthermore, the impact on physicochemical properties of the prepared films with and without yeast cells incorporated were evaluated in terms of thickness, mechanical properties, color and opacity. Chitosan films with the antagonistic yeast entrapped exhibited strong antifungal activity by inhibiting the mycelial development (55%), germination (45%) and reducing the sporulation process (87%). Chitosan matrix at 0.5% and 1.0% was maintained over 9 days of cell viability. However, at 1.5% of chitosan the population dynamics was strongly affected. The addition of yeast cells only impacted color values such as a*, b*, chroma and hue angle when 1.0% of chitosan concentration was used. Conversely, luminosity was not affected in the presence of yeast cells as well as the opacity. Besides, the addition of antagonistic yeast improved the mechanical resistance of the films. The addition of D. hansenii in chitosan films improve their efficacy for controlling P. italicum, and besides showed desirable characteristics for future use as packaging for citrus products.
1. Introduction
Nowadays, the preservation of food is crucial to respond to the high demand of healthy foods as well as consumers’ preference for produce with longer shelf-life [1]. An alternative is the formulation and use of edible packaging films not only for food protection but also as a strategy for using eco-friendly materials in the food industry [2]. In this sense, chitosan is a versatile biopolymer derived from natural resources, biocompatible, with good film-forming ability and antimicrobial activity [3,4]. It is recognized that edible films can be used as carriers of several compounds such as plant extracts [5], colors and flavors [6], essential oils [7], probiotics [8] and microbial antagonists [9,10]. Several studies reported the carrier capacity of chitosan of several compounds such as gallic acid [11], nisin [12], sulfur nanoparticles [13] and essential oils [14], among others. However, to our knowledge, there is no report about the incorporation of marine yeasts Debaryomyces hansenii in chitosan-based films.
On the other hand, antagonists have been used successfully for controlling important pathogens such as Colletotrichum gloeosporioides [15,16], Fusarium proliferatum [17], Botrytis cinerea [18], Penicillium digitatum [19] and Penicillium italicum [20]. Marine yeast Debaryomyces hansenii can control phytopathogens throughout several mechanisms of action such as the synthesis of hydrolytic enzymes (chitinase, glucanase, protease), competition for space and nutrients, production of killer toxins and biofilms onto the fruit surface, thus the use of antagonistic D. hansenii to manage fungal diseases is a promising alternative to chemical management [21,22,23].
It is reported that edible films can improve the biocontrol activity of microbial antagonists [10,24]. In this context, in a recent study, the antagonistic yeast Meyerozyma caribbica was added into sodium alginate-based films; the results showed the inhibition of Colletotrichum gloeosporioides not only in the mycelial growth (100%) but also in the germination process (99%) [25]. In another study, Aloui et al. [26] reported that sodium alginate-based films with the antagonistic yeast Wickerhamomyces anomalus entrapped can control Penicillium digitatum in vitro, by reducing the mycelial development. The objective of this study was to evaluate the impact of the addition of the antagonistic yeast D. hansenii in chitosan-based films in terms of cell viability (population dynamics), antifungal efficacy against P. italicum and physicochemical properties of films.
2. Materials and Methods
2.1. Raw Materials
Commercial chitosan (Molecular weight = 3.01 × 104 Da, cp = 200, 90% of deacetylation, Golden-Shell Pharmaceutical Co., Ltd., Zhejiang, China) was used. Glycerol from Sigma-Aldrich (St. Louis, MO, USA) was used as a plasticizer. Glacial acetic acid and Tween 80 were purchased from Jalmek (San Nicolás de los Garza, Mexico).
2.2. Microorganisms
The antagonistic yeast and the pathogen Penicillium italicum (isolated from Persian lime) were provided by CIBNOR S.C. The yeast was maintained on yeast extract peptone dextrose (YPD) medium [27]. The fungus was maintained on PDA (Potato dextrose agar) plates (Sigma-Aldrich, St. Louis, MO, USA).
2.3. Film Preparation
Chitosan-based films were prepared by a casting method following the protocol proposed by Homez-Jara et al. [28] with some modifications. Chitosan-based film forming solutions were prepared by dissolving 0.5%, 1.0% or 1.5% (w/v) in 1% of glacial acetic acid, glycerol (0.3% v/v) and Tween 80 (0.1% v/v) with constant agitation using magnetic stir at room temperature for 180 min. The chitosan solutions were vacuum filtered and allowed to stand overnight. The film forming solutions (without yeast) were sterilized at 121 °C during 15 min. For the films incorporated with the antagonistic yeast, firstly a solution containing the yeast was prepared: briefly, in a biosafety hood (Novatech BBS-DDC) Petri dishes containing yeasts were scrapped with a sterile inoculation loop, then the yeasts were incorporated into a sterile saline solution (0.85%) and adjusted to 1 × 107 cell/mL. Then, the solution was centrifuged at 6000 rpm for 20 min, the resulting pellet was aseptically removed and incorporated to the sterile chitosan-based film forming solution in sterile conditions. Finally, the film forming solutions with and without yeast were poured into Petri dishes (60 × 15 mm) and they were left to dry for 40 h in an oven at 40 °C (22% of relative humidity).
2.4. Antifungal Test
The mycelial growth inhibition was performed using the protocol proposed by González-Estrada et al. [27] with some modifications. Firstly, the fungus was grown on PDA plates for 7 days (28 °C), then with a sterile inoculation loop; a portion of the fungus mycelia was taken and inoculated in the center of PDA Petri dishes. Thereafter, the surface was covered with chitosan-based films containing or not the antagonistic yeast. Finally, plates were incubated at 28 °C for 6 days, the colony diameter was registered daily using a digital Vernier (Truper S.A. de C.V.™, Villahermosa, Mexico). Control plates consisted of PDA plates without films. The results were registered as percentage of mycelial growth inhibition according to the following formula [27]:
dc (cm) is the mean of colony diameter for the control and dt (cm) is the mean of the colony diameter of treatments. Once the mycelial inhibition test was finished, the same Petri dishes were used for the sporulation test. Briefly, the film was removed aseptically, then sterile distilled water (10 mL) was added to the fungal lawn and the film that was in contact with the colony and was rubbed with an inoculation loop in order to release the spores. The mycelia present in the suspension was retained using a sterile cheesecloth. The spore concentration (number of spores/mL) was calculated using a hemocytometer (Hausser Scientific®, Horsham, PA, USA), the percentage of spore reduction was calculated considering the spore’s concentration of the control plate. A germination test was performed using the protocol proposed by González-Estrada [27] with some modifications. Briefly, 20 µL of the spore suspension (1 × 106 spores/mL) was added into PDA plugs (6 mm), the inoculum was left to dry for 15 min in a biosafety hood, then the plugs were covered with the films containing the antagonistic yeast or not. Control samples consisted of PDA plugs without films. After 12 h of sample incubation the films were removed aseptically in order to quantify the germinated spores using a microscope (Motic, BA300, San Antonio, TX, USA) by counting 200 spores per sample as a reference.
Inhibition (%) = [(dc − dt)/dc] × 100.
2.5. Viability of D. hansenii in Films
For the evaluation of yeast’s viability the protocol proposed by González-Estrada et al., (2017) was applied with some modifications: films were aseptically cut and placed into a sterile saline solution (0.85%), stirred (350 rpm) at room temperature for 48 h until the film was dissolved in order to release the cells from the film. Serial dilutions were made and 100 µL of sample was inoculated on YPD and incubated for 24 h at 28 °C, and finally the number of viable yeasts were counted. The results were expressed as Log CFU/film.
2.6. Film Characterization: Physicochemical Properties
2.6.1. Thickness
The thicknesses of each film were measured using a digital micrometer (Fowler Electronic Micrometer, Newton, MA, USA) at ten randomly selected points on each sample [29].
2.6.2. Mechanical Properties
The tensile test evaluated in the films were stress at break (MPa), strain at break (%) and Young’s Modulus (MPa), following the method ASTM D-88-02 [30]. Stress at break is the maximum stress supported by a material and is estimated by dividing the maximum load by the cross-sectional area of the initial sample. Strain at break is the percentage change in the length of the sample from the original length (L) between grips (20 mm). Young’s modulus is calculated from the initial linear slope of the stress-strain curve. The mechanical properties were evaluated in a texture analyzer (TAXT plus, Vienna Court, Surrey, UK). Films were cut into 4.0 × 0.5 cm strips and were analyzed under a tension force with a load cell of 50 N and a crosshead speed of 1 mm/min.
2.6.3. Optical Properties
Color Assessments
Chitosan-based films color was evaluated with a colorimeter (PCE-CSM 7). The color coordinates, L (lightness), a* (red–green) and b* (yellow–blue) were used to determine the Chroma () and hue angle () and color change , induced by the presence of yeast in films, using the following equations:
Opacity
The opacity was calculated based on average thickness. This determination was evaluated following the protocol proposed by Souza et al. [29], using rectangular samples from each film and using a UV/VIS spectrophotometer (Thermo Scientific GENESYS 10S, Waltham, MA, USA) at 600 nm, the opacity was calculated using the following formula:
2.7. Statistical Analysis
A factorial design (2 × 3) was applied for the analysis of data for in vitro tests, thickness and optical properties, taking into account the presence or not of antagonistic yeast and chitosan concentration (0.5, 1.0 and 1.5%). For mycelial growth and sporulation assays five Petri dishes were used and for germination assay five PDA disks were used per replicate. For thickness and optical properties, three films were used per replicate. Uni-factorial statistical design was applied for population dynamics in films, three films were used per replicate. All the experiments were repeated twice. The Analysis of variance (ANOVA) with a statistical significance of 5% was conducted using Minitab Statistical Software® (version 19.2020.1.0, Minitab, LLC, Chicago, IL, USA). The LSD test was used to determine significant differences among chitosan concentration and the presence or not of antagonistic yeast.
3. Results
3.1. Antifungal Test
The antifungal activity of elaborated films against P. italicum is shown in Figure 1 and Figure 2. Overall, efficacy of films was significant (p < 0.05) depending on the chitosan concentration and the presence or not of the antagonistic yeast. The application of chitosan-based films at 1.5% with yeast was more efficient to control mycelial development (55%) compared to films without yeasts (37%).
Figure 1.
Mycelial development of Penicillium italicum exposed to chitosan-based films for 6 days.
Figure 2.
Effect of chitosan-based films with or without antagonistic yeasts against Penicillium italicum development, (a) mycelial growth, (b) germination, (c) sporulation and (d) sporulation reduction. According to the LSD test, different letters indicate significant differences (p < 0.05) among chitosan concentration (upper-case) and presence or not of antagonistic yeast (lower-case). Values are expressed as means ± standard deviation.
Germination of P. italicum was mostly inhibited with the application of chitosan-based films (1.5%) with antagonistic yeasts entrapped (45%) compared to films without yeasts (30%).
The sporulation process was strongly affected at all concentrations of chitosan evaluated in combination with the antagonistic yeast (Figure 2c,d). For films with the yeast, entrapped lower values of spores/mL were reported (4.5 × 106), reducing the sporulation process by up to 81%; conversely, chitosan films without yeast reported 3.2 × 107 of spores/mL and a sporulation reduction of 12%.
3.2. Population Dynamics of Yeast in Films
The effect of chitosan on the growth of antagonistic yeast was evaluated on the population dynamics of D. hansenii in films. Depending on chitosan concentration, the viability of yeast was decreasing over the storage time (Figure 3). On the 6th day with 0.5% of chitosan the population dynamics was maintained 100%. Conversely, with 1.0% of chitosan, 75% of the initial inoculum was preserved. On the 9th day the inoculum was maintained at 62% and 24%, for 0.5% and 1.0% of chitosan respectively. Conversely, with 1.5% of chitosan on the sixth day no viability was evidenced.
Figure 3.
Population dynamics of D. hansenii entrapped in chitosan films. According to the LSD test, different letters indicate significant differences (p < 0.05). Values are expressed as means ± standard deviation.
3.3. Film Characterization: Physicochemical Properties
The basic film properties, including thickness, mechanical properties, color and opacity, are shown in Table 1 and Table 2. Film thickness was only significantly affected (p < 0.05) by the chitosan concentration, as previously reported [28], but not for the addition of yeast cells. Film luminosity decreased as the chitosan concentration increased, as previously reported [31]. Conversely, the incorporation of yeasts had no effect on the film’s lightness. Parameter a* had positive values, which means that a red color was noted in lesser or greater intensity depending on the chitosan concentration. Besides, only significant changes were noted in this parameter in films at 1.0% of chitosan with yeast (3.4) compared to films without yeast (2.9). The b* values significantly increased according to the chitosan concentration (p < 0.05), indicating that the films were yellower (Figure 4), as previously reported [28]. Besides, only changes in b* values were noted by the addition of yeasts (12.9) compared to films without yeasts (9.7) at 1.0% of chitosan concentration. Hence, chitosan films with and without yeasts became slightly reddish and yellowish, but they were still transparent (Figure 4). For chroma values, an increase according to chitosan concentration was noted, whereas the incorporation of D. hansenii in the polymeric matrix was only significant (p < 0.05) at 1.0% of chitosan concentration. The same behavior was noted for hue angle in films with yeasts (at 1.0% of chitosan), whereas at 0.5% and 1.5% of chitosan the addition of yeast did not change this parameter. Significant changes (p < 0.05) were noted on depending on chitosan concentration; conversely, the presence of yeast only impacted this value at low chitosan concentrations (0.5%). The opacity is an inverse measure of transparency; thus, the transparency decreases as its opacity increases. The opacity values were observed range from 2.5 to 4.82 mm−1 in films without yeasts and 3.3 to 7.4 mm−1 in films with yeasts.
Table 1.
Thickness and tensile properties of chitosan films with or without yeasts.
Table 2.
Optical properties of chitosan films with or without yeasts.
Figure 4.
Chitosan-based films with or without marine yeast.
The effects of incorporating yeast on the tensile properties of chitosan films are presented in Table 1. According to statistical analysis results, both the concentration and the yeast addition showed a significant effect for stress at break and Young’s modulus (p < 0.0001). Both parameters increased with the concentration of chitosan in the films. It is observed that when the yeasts were added to the films, the stress at break increased by nearly double; this effect was more evident at a higher concentration of chitosan (1.5% chitosan, 10.92 ± 1.68 MPa). Similarly, Young’s modulus increased significantly when yeasts were incorporated into the chitosan matrix. For the maximum chitosan concentration (1.5%), Young’s modulus increased by around 250% (6.51 ± 0.76 MPa) compared to the film without yeast (2.54 ± 0.37 MPa).
Strain at break also increased significantly with higher chitosan concentration. However, the addition of yeast into the films did not show a significant effect (p = 0.0686). In Table 1 it is observed that in chitosan-yeast films (1.5%) the strain at break was 3.98%, which corresponds to a decrease of 29% compared to the chitosan films (without yeast, 5.14 ± 0.55%).
4. Discussion
Chitosan has the ability to induce the permeabilization of cell membranes leading to the loss of cell content, besides this interaction causes biochemical alterations such as protein biosynthesis, carbohydrate metabolism and energy production in the fungus affecting the mycelial development [32,33]. On the other hand, D. hansenii has the ability to produce lytic enzymes (protease, glucanase and chitinase) which are related to their antifungal activity; these enzymes can interact with the cell wall of P. italicum causing their degradation [23,34]. The results showed a better efficacy by the combination of chitosan with the antagonistic yeast (Figure 1), previous studies have reported a synergistic effect of chitosan against pathogens when the biopolymer is combined with antagonistic yeasts, due to a better distribution of the antagonistic cells that can be in contact with the pathogen allowing the production of lytic enzymes, as previously reported [27,35,36,37,38].
Chitosan inhibition could be related to the electrostatic forces between the amino groups (-NH2) of chitosan with the negative charges on the cell membrane of the spore, causing changes in its permeability and alterations at the intracellular level, affecting the germination process [3]. Nevertheless, the efficacy was better for films with the D. hansenii entrapped, in this sense two mechanisms of action such as hydrolytic enzymes and nutrient competition are related to the affectation of spore development of P. italicum avoiding the tube elongation, as previously reported [27,39]. Our results are in agreement with those reported by Wang et al. [36]. In their investigation, the combination of carboxymethyl chitosan with Cryptococcus laurentii was more efficient for inhibiting not only the germination process of P. italicum but also the germ tube length than a single application of chitosan.
The results of the sporulation can be related to the damage in the mycelia, even when with chitosan films at 0.5% and 1.0% and with the antagonistic yeast entrapped, lower values of mycelial development were reported (Figure 2a), the results suggest a significant damage to fungus structure that affects spore production. P. italicum is considered one of the most devastating pathogens for citrus fruits, causing blue mold decay [40]. Germination and sporulation as well as mycelial growth play a key role in the infection cycle of P. italicum in citrus, thus any treatment with antifungal activity is crucial to affect the establishment of the fungus in susceptible fruits [41].
In the population dynamics our results are in agreement with previous reports, the same effect has been evidenced for Cryptococcus laurentii exposed to carboxymethyl chitosan [36] and chitosan [42]. However, in both studies the exposition with chitosan was temporal (24 h), thus our results are better due to the maintenance of viability for 5 days more and even at high concentrations of chitosan.
The study of mechanical properties in coatings and food packaging is extremely important since the packaging must resist mechanical stress to protect the food and be able to maintain its integrity during handling. Chitosan composition and intermolecular forces play an important role in the mechanical properties of chitosan-based films [43]. It is also important to consider the compatibility of the chitosan with the other components in the film. The increase in stress at break is related to good interaction between polymers, improving the mechanical resistance of the films. Likewise, increasing elongation results in better ductility. Koc et al. [44] studied the mechanical properties in chitosan-fungal extract films (Trichholoma terreum). The elasticity of the chitosan films was increased with the addition of the fungal extract. On the contrary, tensile strength and Young’s modulus decreased. This behavior was attributed to the interaction between the chitosan polymer chains with the fungal extract molecules.
Similarly, González-Estrada et al. [9] added D. hansenni yeast to covalently cross-linked arabinoxylans films. The evaluation of the mechanical properties of the films showed that tensile strength, elongation at break and Young’s modulus values decreased when D. hansenii was added to the film. They reported that changes in the mechanical properties were due to defects in the arabinoxylans films, which contribute to an early rupture of the films during tensile tests.
β-glucans are the main structural components of the cell wall in yeasts. The D. hansenni cell wall was characterized by Medina-Córdova et al. [45] using NMR. They found structures containing (1-6)-branched (1-3)-β-D-glucan. The interaction between chitosan and β-glucans in films has been previously reported. Koc et al. [44] studied the interactions between a fungal extract and polyphenols in a chitosan matrix. FTIR spectra indicated that the OH absorption peak was broadened and shifted towards lower frequencies due to the formation of hydrogen bonds between the chitosan film matrix, β-glucan and polyphenolic compounds. In our study, stress at break increased with the addition of yeast, which could indicate the presence of interactions and good compatibility between molecules (e.g., chitosan molecules and yeast β-glucans). Thus, enhancing mechanical resistance of the films. The decrease in strain at break showed by films with 1.5% chitosan + yeast might be due to the higher number of interactions between the yeast and the functional groups in chitosan when the latter polymer is at a higher concentration. Thus, the free volume and molecular mobility of the polymer chains are decreased. This behavior has been previously observed in chitosan films incorporated with essential oils [46,47] and polyphenols [43]. In this work, the concentration of chitosan and the addition of yeasts improved the mechanical properties of the films. Mechanical resistance was improved while maintaining ductility, therefore these materials could be used as edible films to control the growth of pathogens and improve the safety and quality of food.
In color parameters, our results are in agreement with González-Estrada et al. [9], whose study reported changes in color values such as a* and b* in arabinoxylan films with D. hansenii entrapped. The opacity and values showed that the addition of yeasts only impacted films with a low concentration of chitosan (0.5%), conversely at 1.0% and 1.5% of chitosan no changes were observed. The opacity values of this study agreed with those reported by Homez-Jara et al. [28], ranging from 2.4 to 5.1 mm−1. Color and transparency of films are crucial factors of packaging materials in which the visual characteristic can impact consumer acceptance [48]. Future research is needed considering the use of chitosan combined with the antagonistic yeast as a coating on citrus.
5. Conclusions
In conclusion, chitosan combined with D. hansenii proved to be more successful at inhibiting the growth of fungi in vitro than the application of chitosan alone. At 0.5% and 1.0% of chitosan concentration, the viability of yeast was maintained for 9 days. The incorporation of antagonistic yeast improved the mechanical resistance of the films. Chitosan in combination with yeast not only achieves the viability of the antagonist, but also shows important effects on parameters involved in the development and proliferation of the fungus. In addition, the films have desirable characteristics for packaging use for citrus in the future. Nevertheless, the combined use of chitosan at 0.5% and 1.0% with the antagonistic yeast needs to be tested in in vivo trials on citrus fruit, in order to determine if the resulting population dynamics is sufficient to prevent fungal infection by Penicillium italicum.
Author Contributions
Conceptualization, C.A.G.-B.; Data curation, L.M.M.-C.; Formal analysis, L.M.M.-C.; Funding acquisition, R.R.G.-E.; Supervision, P.G.-M.; Writing—original draft, C.A.G.-B. and B.M.-L.; Writing—review and editing, F.J.B.-B. and R.R.G.-E. All authors have read and agreed to the published version of the manuscript.
Funding
This research was funded by Tecnológico Nacional de México, grant number 10324.21-P.
Institutional Review Board Statement
Not applicable.
Informed Consent Statement
Not applicable.
Data Availability Statement
The datasets generated during the study are availabe from the corresponding authors upon reasonable request.
Acknowledgments
The authors are pleased to acknowledge Felipe J. Ascencio-Valle of CIBNOR by providing antagonistic yeast.
Conflicts of Interest
The authors declare no conflict of interest.
References
- Abdollahzadeh, E.; Nematollahi, A.; Hosseini, H. Composition of Antimicrobial Edible Films and Methods for Assessing Their Antimicrobial Activity: A Review. Trends Food Sci. Technol. 2021, 100, 291–303. [Google Scholar] [CrossRef]
- Díaz-Montes, E.; Castro-Muñoz, R. Edible Films and Coatings as Food-Quality Preservers: An Overview. Foods 2021, 10, 249. [Google Scholar] [CrossRef]
- Elsabee, M.Z.; Abdou, E.S. Chitosan Based Edible Films and Coatings: A Review. Mater. Sci. Eng. C 2013, 33, 1819–1841. [Google Scholar] [CrossRef]
- Romanazzi, G.; Feliziani, E.; Sivakumar, D. Chitosan, a Biopolymer with Triple Action on Postharvest Decay of Fruit and Vegetables: Eliciting, Antimicrobial and Film-Forming Properties. Front. Microbiol. 2018, 9, 2745. [Google Scholar] [CrossRef]
- Aloui, H.; Deshmukh, A.R.; Khomlaem, C.; Kim, B.S. Novel Composite Films Based on Sodium Alginate and Gallnut Extract with Enhanced Antioxidant, Antimicrobial, Barrier and Mechanical Properties. Food Hydrocoll. 2021, 113, 106508. [Google Scholar] [CrossRef]
- Han, J.H. Edible films and coatings: A review. In Innovations in Food Packaging, 2nd ed.; Elsevier: Houston, TX, USA, 2014; pp. 213–255. [Google Scholar]
- Ebrahimzadeh, S.; Bari, M.R.; Hamishehkar, H.; Kafil, H.S.; Lim, L.-T. Essential Oils-Loaded Electrospun Chitosan-Poly (Vinyl Alcohol) Nonwovens Laminated on Chitosan Film as Bilayer Bioactive Edible Films. LWT 2021, 111217. [Google Scholar] [CrossRef]
- Pop, O.L.; Pop, C.R.; Dufrechou, M.; Vodnar, D.C.; Socaci, S.A.; Dulf, F.V.; Minervini, F.; Suharoschi, R. Edible Films and Coatings Functionalization by Probiotic Incorporation: A Review. Polymers 2020, 12, 12. [Google Scholar] [CrossRef] [PubMed] [Green Version]
- González-Estrada, R.; Calderón-Santoyo, M.; Carvajal-Millan, E.; De Jesús Ascencio Valle, F.; Ragazzo-Sánchez, J.A.; Brown-Bojorquez, F.; Rascón-Chu, A. Covalently Cross-Linked Arabinoxylans Films for Debaryomyces hansenii Entrapment. Molecules 2015, 20, 11373–11386. [Google Scholar] [CrossRef] [Green Version]
- Marín, A.; Atarés, L.; Chiralt, A. Improving Function of Biocontrol Agents Incorporated in Antifungal Fruit Coatings: A Review. Biocontrol Sci. Technol. 2017, 27, 1220–1241. [Google Scholar] [CrossRef]
- Zarandona, I.; Puertas, A.I.; Dueñas, M.T.; Guerrero, P.; de la Caba, K. Assessment of Active Chitosan Films Incorporated with Gallic Acid. Food Hydrocoll. 2020, 101, 105486. [Google Scholar] [CrossRef]
- Zimet, P.; Mombrú, Á.W.; Mombrú, D.; Castro, A.; Villanueva, J.P.; Pardo, H.; Rufo, C. Physico-Chemical and Antilisterial Properties of Nisin-Incorporated Chitosan/Carboxymethyl Chitosan Films. Carbohydr. Polym. 2019, 219, 334–343. [Google Scholar] [CrossRef] [PubMed]
- Shankar, S.; Rhim, J.-W. Preparation of Sulfur Nanoparticle-Incorporated Antimicrobial Chitosan Films. Food Hydrocoll. 2018, 82, 116–123. [Google Scholar] [CrossRef]
- Lian, H.; Peng, Y.; Shi, J.; Wang, Q. Effect of Emulsifier Hydrophilic-Lipophilic Balance (HLB) on the Release of Thyme Essential Oil from Chitosan Films. Food Hydrocoll. 2019, 97, 105213. [Google Scholar] [CrossRef]
- Rivas-Garcia, T.; Murillo-Amador, B.; Nieto-Garibay, A.; Chiquito-Contreras, R.; Rincon-Enriquez, G.; Hernandez-Montiel, L. Effect of Ulvan on the Biocontrol Activity of Debaryomyces hansenii and Stenotrophomonas rhizophila against Fruit Rot of Cucumis melo L. Agronomy 2018, 8, 273. [Google Scholar] [CrossRef] [Green Version]
- Reyes, J.J.; Vero, S.; Diaz-Rivera, E.; LARA, L.L.-C.; Noa, J.; Hernandez, L. Application of Chlorine Dioxide (ClO2) and Marine Yeasts to Control Postharvest Anthracnose Disease in Mango (Mangifera indica L.). Cienc. Investig. Agrar. 2019, 46, 266–275. [Google Scholar] [CrossRef]
- Rivas-Garcia, T.; Murillo-Amador, B.; Nieto-Garibay, A.; Rincon-Enriquez, G.; Chiquito-Contreras, R.G.; Hernandez-Montiel, L.G. Enhanced Biocontrol of Fruit Rot on Muskmelon by Combination Treatment with Marine Debaryomyces hansenii and Stenotrophomonas rhizophila and Their Potential Modes of Action. Postharvest Biol. Technol. 2019, 151, 61–67. [Google Scholar] [CrossRef]
- Chen, P.-H.; Chen, R.-Y.; Chou, J.-Y. Screening and Evaluation of Yeast Antagonists for Biological Control of Botrytis Cinerea on Strawberry Fruits. Mycobiology 2018, 46, 33–46. [Google Scholar] [CrossRef] [PubMed] [Green Version]
- Chen, O.; Yi, L.; Deng, L.; Ruan, C.; Zeng, K. Screening Antagonistic Yeasts against Citrus Green Mold and the Possible Biocontrol Mechanisms of Pichia Galeiformis (BAF03). J. Sci. Food Agric. 2020, 100, 3812–3821. [Google Scholar] [CrossRef]
- Wang, Z.; Li, J.; Liu, J.; Tian, X.; Zhang, D.; Wang, Q. Management of Blue Mold (Penicillium italicum) on Mandarin Fruit with a Combination of the Yeast, Meyerozyma guilliermondii and an Alginate oligosaccharide. Biol. Control 2021, 152, 104451. [Google Scholar] [CrossRef]
- Hernandez-Montiel, L.G.; Droby, S.; Preciado-Rangel, P.; Rivas-García, T.; González-Estrada, R.R.; Gutiérrez-Martínez, P.; Ávila-Quezada, G.D. A Sustainable Alternative for Postharvest Disease Management and Phytopathogens Biocontrol in Fruit: Antagonistic Yeasts. Plants 2021, 10, 2641. [Google Scholar] [CrossRef] [PubMed]
- Droby, S.; Gonzalez-Estrada, R.R.; Avila-Quezada, G.; Durán, P.; Manzo-Sánchez, G.; Hernandez-Montiel, L.G. Microbial Antagonists from Different Environments Used in the Biocontrol of Plant Pathogens. In Microbial Biocontrol: Food Security and Post Harvest Management; Springer: Cham, Switzerland, 2022; pp. 227–244. [Google Scholar]
- Medina-Córdova, N.; Rosales-Mendoza, S.; Hernández-Montiel, L.G.; Angulo, C. The Potential Use of Debaryomyces hansenii for the Biological Control of Pathogenic Fungi in Food. Biol. Control 2018, 121, 216–222. [Google Scholar] [CrossRef]
- Guimaraes, A.; Abrunhosa, L.; Pastrana, L.M.; Cerqueira, M.A. Edible Films and Coatings as Carriers of Living Microorganisms: A New Strategy towards Biopreservation and Healthier Foods. Compr. Rev. Food Sci. Food Saf. 2018, 17, 594–614. [Google Scholar] [CrossRef] [PubMed] [Green Version]
- Iñiguez-Moreno, M.; Ragazzo-Sánchez, J.A.; Barros-Castillo, J.C.; Sandoval-Contreras, T.; Calderón-Santoyo, M. Sodium Alginate Coatings Added with Meyerozyma caribbica: Postharvest Biocontrol of Colletotrichum Gloeosporioides in Avocado (Persea americana Mill. Cv. Hass). Postharvest Biol. Technol. 2020, 163, 111123. [Google Scholar] [CrossRef]
- Aloui, H.; Licciardello, F.; Khwaldia, K.; Hamdi, M.; Restuccia, C. Physical Properties and Antifungal Activity of Bioactive Films Containing Wickerhamomyces anomalus Killer Yeast and Their Application for Preservation of Oranges and Control of Postharvest Green Mold Caused by Penicillium digitatum. Int. J. Food Microbiol. 2015, 200, 22–30. [Google Scholar] [CrossRef] [PubMed]
- González-Estrada, R.R.; Carvajal-Millán, E.; Ragazzo-Sánchez, J.A.; Bautista-Rosales, P.U.; Calderón-Santoyo, M. Control of Blue Mold Decay on Persian Lime: Application of Covalently Cross-Linked Arabinoxylans Bioactive Coatings with Antagonistic Yeast Entrapped. LWT-Food Sci. Technol. 2017, 85, 187–196. [Google Scholar] [CrossRef]
- Homez-Jara, A.; Daza, L.D.; Aguirre, D.M.; Muñoz, J.A.; Solanilla, J.F.; Váquiro, H.A. Characterization of Chitosan Edible Films Obtained with Various Polymer Concentrations and Drying Temperatures. Int. J. Biol. Macromol. 2018, 113, 1233–1240. [Google Scholar] [CrossRef] [PubMed]
- Souza, V.G.L.; Fernando, A.L.; Pires, J.R.A.; Rodrigues, P.F.; Lopes, A.A.S.; Fernandes, F.M.B. Physical Properties of Chitosan Films Incorporated with Natural Antioxidants. Ind. Crops Prod. 2017, 107, 565–572. [Google Scholar] [CrossRef]
- ASTM D882-01; Standard Test Method for Tensile Properties of Thin Plastic Sheeting. American Society for Testing Materials: Philadelphia, PA, USA, 2001.
- García, M.A.; Pérez, L.; de la Paz, N.; González, J.; Rapado, M.; Casariego, A. Effect of Molecular Weight Reduction by Gamma Irradiation on Chitosan Film Properties. Mater. Sci. Eng. C 2015, 55, 174–180. [Google Scholar] [CrossRef]
- Abd El-Hack, M.E.; El-Saadony, M.T.; Shafi, M.E.; Zabermawi, N.M.; Arif, M.; Batiha, G.E.; Khafaga, A.F.; Abd El-Hakim, Y.M.; Al-Sagheer, A.A. Antimicrobial and Antioxidant Properties of Chitosan and Its Derivatives and Their Applications: A Review. Int. J. Biol. Macromol. 2020, 164, 2726–2744. [Google Scholar] [CrossRef]
- Li, M.; Chen, C.; Xia, X.; Garba, B.; Shang, L.; Wang, Y. Proteomic Analysis of the Inhibitory Effect of Chitosan on Penicillium expansum. Food Sci. Technol. 2020, 40, 250–257. [Google Scholar] [CrossRef] [Green Version]
- Hernández-Montiel, L.G.; Ochoa, J.L.; Troyo-Diéguez, E.; Larralde-Corona, C.P. Biocontrol of Postharvest Blue Mold (Penicillium italicum Wehmer) on Mexican Lime by Marine and Citrus Debaryomyces hansenii Isolates. Postharvest Biol. Technol. 2010, 56, 181–187. [Google Scholar] [CrossRef]
- Yu, T.; Li, H.Y.; Zheng, X.D. Synergistic Effect of Chitosan and Cryptococcus Laurentii on Inhibition of Penicillium expansum Infections. Int. J. Food Microbiol. 2007, 114, 261–266. [Google Scholar] [CrossRef]
- Wang, F.; Deng, J.; Jiao, J.; Lu, Y.; Yang, L.; Shi, Z. The Combined Effects of Carboxymethyl Chitosan and Cryptococcus Laurentii Treatment on Postharvest Blue Mold Caused by Penicillium italicum in Grapefruit Fruit. Sci. Hortic. 2019, 253, 35–41. [Google Scholar] [CrossRef]
- Zhou, Y.; Zhang, L.; Zeng, K. Efficacy of Pichia membranaefaciens Combined with Chitosan against Colletotrichum gloeosporioides in Citrus Fruits and Possible Modes of Action. Biol. Control 2016, 96, 39–47. [Google Scholar] [CrossRef]
- Aloui, H.; Khwaldia, K.; Sánchez-González, L.; Muneret, L.; Jeandel, C.; Hamdi, M.; Desobry, S. Alginate Coatings Containing Grapefruit Essential Oil or Grapefruit Seed Extract for Grapes Preservation. Int. J. Food Sci. Technol. 2014, 49, 952–959. [Google Scholar] [CrossRef]
- González Estrada, R.R.; Ascencio Valle, F.D.J.; Ragazzo Sánchez, J.A.; Calderón Santoyo, M. Use of a Marine Yeast as a Biocontrol Agent of the Novel Pathogen Penicillium citrinum on Persian Lime. Emir. J. Food Agric. 2017, 29, 114–122. [Google Scholar] [CrossRef] [Green Version]
- Palou, L. Penicillium digitatum, Penicillium italicum (Green Mold, Blue Mold). In Postharvest Decay; Elsevier: San Diego, CA, USA, 2014; pp. 45–102. [Google Scholar]
- Kanashiro, A.M.; Akiyama, D.Y.; Kupper, K.C.; Fill, T.P. Penicillium italicum: An Underexplored Postharvest Pathogen. Front. Microbiol. 2020, 11, 3024. [Google Scholar] [CrossRef] [PubMed]
- Yu, T.; Yu, C.; Chen, F.; Sheng, K.; Zhou, T.; Zunun, M.; Abudu, O.; Yang, S.; Zheng, X. Integrated Control of Blue Mold in Pear Fruit by Combined Application of Chitosan, a Biocontrol Yeast and Calcium Chloride. Postharvest Biol. Technol. 2012, 69, 49–53. [Google Scholar] [CrossRef]
- Sun, L.; Sun, J.; Chen, L.; Niu, P.; Yang, X.; Guo, Y. Preparation and Characterization of Chitosan Film Incorporated with Thinned Young Apple Polyphenols as an Active Packaging Material. Carbohydr. Polym. 2017, 163, 81–91. [Google Scholar] [CrossRef] [PubMed] [Green Version]
- Koc, B.; Akyuz, L.; Cakmak, Y.S.; Sargin, I.; Salaberria, A.M.; Labidi, J.; Ilk, S.; Cekic, F.O.; Akata, I.; Kaya, M. Production and Characterization of Chitosan-Fungal Extract Films. Food Biosci. 2020, 35, 100545. [Google Scholar] [CrossRef]
- Medina-Córdova, N.; Reyes-Becerril, M.; Ascencio, F.; Castellanos, T.; Campa-Córdova, A.I.; Angulo, C. Immunostimulant Effects and Potential Application of β-Glucans Derived from Marine Yeast Debaryomyces hansenii in Goat Peripheral Blood Leucocytes. Int. J. Biol. Macromol. 2018, 116, 599–606. [Google Scholar] [CrossRef]
- Hosseini, M.H.; Razavi, S.H.; Mousavi, M.A. Antimicrobial, Physical and Mechanical Properties of Chitosan-based Films Incorporated with Thyme, Clove and Cinnamon Essential Oils. J. Food Processing Preserv. 2009, 33, 727–743. [Google Scholar] [CrossRef]
- Priyadarshi, R.; Kumar, B.; Deeba, F.; Kulshreshtha, A.; Negi, Y.S. Chitosan Films Incorporated with Apricot (Prunus armeniaca) Kernel Essential Oil as Active Food Packaging Material. Food Hydrocolloids 2018, 85, 158–166. [Google Scholar] [CrossRef]
- Chakravartula, S.S.N.; Soccio, M.; Lotti, N.; Balestra, F.; Dalla Rosa, M.; Siracusa, V. Characterization of Composite Edible Films Based on Pectin/Alginate/Whey Protein Concentrate. Materials 2019, 12, 2454. [Google Scholar] [CrossRef] [PubMed] [Green Version]
Publisher’s Note: MDPI stays neutral with regard to jurisdictional claims in published maps and institutional affiliations. |
© 2022 by the authors. Licensee MDPI, Basel, Switzerland. This article is an open access article distributed under the terms and conditions of the Creative Commons Attribution (CC BY) license (https://creativecommons.org/licenses/by/4.0/).